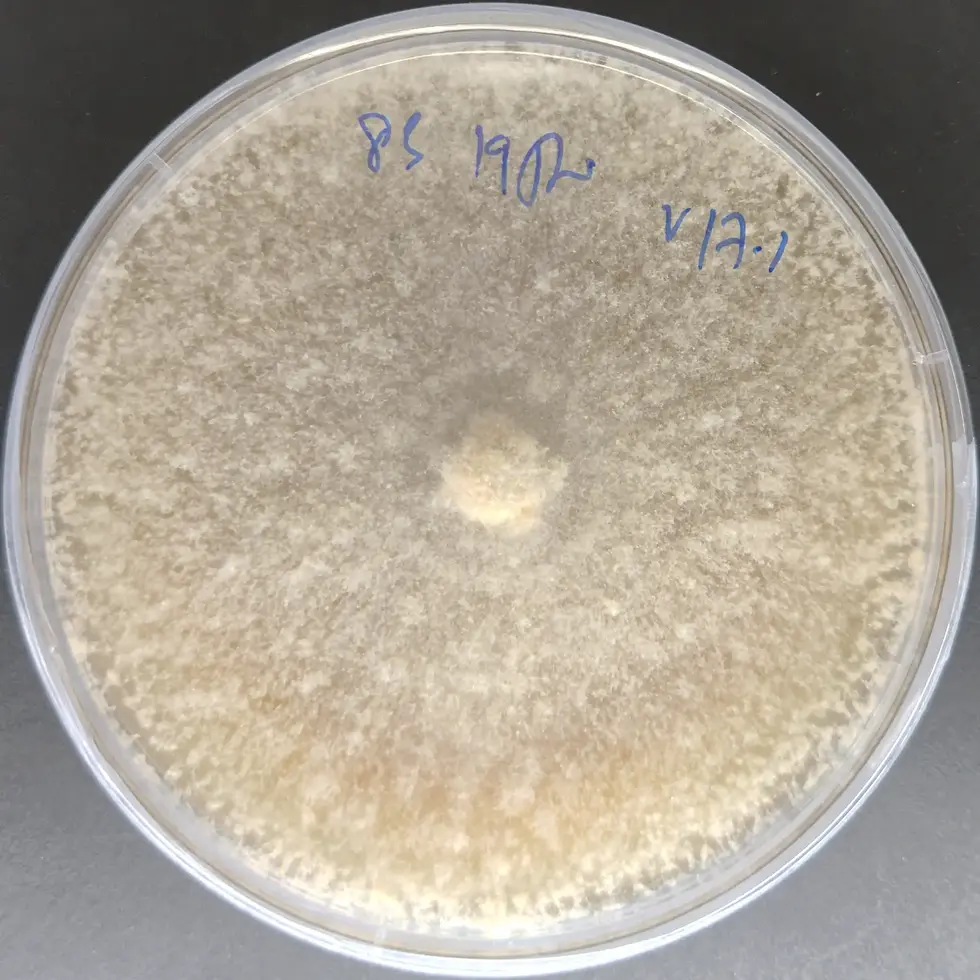
Black Morel Culture Plate (Morchella importuna) in India

Products
All Products
We make every effort to keep our culture availability information up to date. However, certain lesser-used or rare mushroom cultures may occasionally be unavailable in ready-to-use formats (agar plates or liquid culture syringes) for immediate dispatch.
These cultures are often maintained in long-term storage formats within our culture bank depository and can be prepared on request. Lead times typically range from 2–4 weeks, depending on the mushroom species and culture recovery requirements.
We kindly request customers to confirm availability with us prior to placing an order for lesser-used or rare mushroom cultures.
🚫 Out-of-Stock Culture Notice
The following mushroom cultures are currently out of stock and not available for purchase while listed below:
-
Agaricus subrufescens – Almond Mushroom
-
Boletus edulis – Porcini Mushroom
-
Fomes fomentarius – Hoof Fungus
-
Morchella purpurascens – Purple Morel
-
Morchella esculenta – Yellow Morel
-
Stropharia rugoso-annulata – Wine Cap
-
Tremella fuciformis – Snow Fungus
These cultures will remain unavailable until they are restored to active production. Availability status will be updated once they are back in stock.
For enquiries regarding future availability or alternative cultures, please contact us before placing an order.